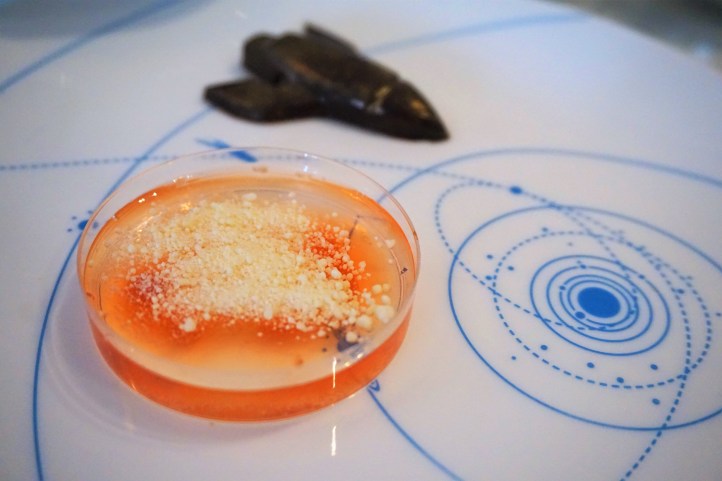

Rediscover science and imagination in a cross-generational afternoon tea.
Our experience
As we have no doubt previously mentioned, afternoon tea is something that these Dessert Correspondents always schedule whenever we are stopping by London. Truly, no one does afternoon tea better than the English. Situated at the border of Kensington and Belgravia, on a recent trip to London, we visited the Ampersand Hotel for their award-winning science-themed afternoon tea. With a Georgian mansion facade, the Ampersand Hotel – at first glance – appears to be all upper-crust British traditionalism. Exhale, not so.

Afternoon tea takes place in an airy, street-facing, and eclectic-modern parlour floor, adorned with rich emerald and cobalt blue velvet-upholstered seats contrasting with graphic wallpaper. Dining ware was plain, standard white, and the accompanying tea menu was moderately extensive. Afternoon tea commenced with a palate cleanser of DIY lemonade. Arriving in a silver tray of doctor’s instruments, we mixed a pipette of blue sugar syrup with tangy lemon juice. This definitely redefined the meaning of visiting the doctor’s while on holiday!

At the Ampersand, the wait staff relished presenting afternoon tea like a West End musical. Lights, camera, smoke! Served with the traditional three tiers, savoury bites featured on the bottom platter, followed by scones, then the sweet irresistibles setting up the finale to the experience. Savouries included blinis smeared with smoked salmon and avocado, two brioche mini-buns (one being roast beef and watercress, and the other a creamy chicken with basil lemon mayonnaise), and a mushroom truffle tartlet. Scones were of two varieties – white chocolate studded with cranberry, and plain – and accompanied with small pots of Devonshire clotted cream, strawberry preserve, and the cutest toothpaste tube of lemon curd.


Long-time followers will know that these Dessert Correspondents seek out afternoon tea venues that put more effort into their dessert creations. Well, we were very, rather pleased with such creations at the Ampersand. Recalling memories of high school chemistry classes growing bacteria and fungi – but so much more edible – the strawberry and elderflower jelly encased in a Petri dish was an ode to springtime in London. Having had a childhood dream of becoming an archaeologist, we especially loved the experience of having to brush through chocolate soil, pop rocks and freeze dried raspberries to uncover a dinosaur shortbread and chocolate seashells. The other desserts followed an intergalactic theme: a chocolate bite shaped as a spaceship, a blueberry and yuzu macaron resembling a spotty meteorite, an incredibly rich dark chocolate and raspberry Saturn mousse ball, and a crescent moon-shaped coconut chocolate cake.

Our verdict
Afternoon tea shouldn’t just be the exclusive territory for grandmas with pearl strands and tweed coats, ladies with Hermes neck scarves who shop and lunch, or the once-in-a-lifetime wedding showers. For children and adults alike, London’s Ampersand Hotel offers a splendid, artistically-realized journey into the world of scientific imagination and wonders.
Dessert adventure checklist
- ☑ Dessert destination: Ampersand Hotel, 10 Harrington Road, Kensington, London.
- ☑ Budget: $$$ (GBP 39.50).
- ☑ Sweet irresistibles: Afternoon Tea.
- ☑ Must-eat: The chocolate raspberry mousse Saturn, dinosaur fossil shortbread, and lemon curd squeeze tube on scones.
- ☑ The short and sweet story: Rediscover science and imagination in a cross-generational afternoon tea.
